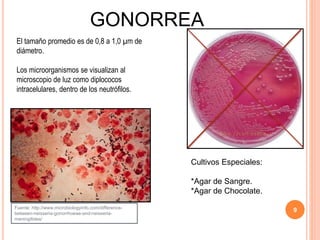
GONORREA
El tamaño promedio es de 0,8 a 1,0 µm de
diámetro.
Los microorganismos se visualizan al
microscopio de luz como diplococos
intracelulares, dentro de los neutrófilos.
9Fuente: http://www.microbiologyinfo.com/difference-
between-neisseria-gonorrhoeae-and-neisseria-
meningitides/
Cultivos Especiales:
*Agar de Sangre.
*Agar de Chocolate.

Este documento describe la gonorrea, una infección causada por la bacteria Neisseria gonorrhoeae. Explica que la gonorrea puede infectar las mucosas genitales y otras áreas del cuerpo, y que a menudo no muestra síntomas en las mujeres. También presenta dos casos clínicos de pacientes tratados por gonorrea y resume los tratamientos comunes como cefriaxona y ofloxacina.